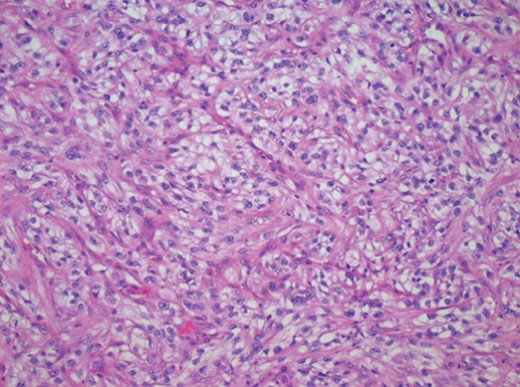
Photomicrograph of a specimen from the lower lip demonstrating the presence of RCC cells.

-
PDF
- Split View
-
Views
-
Cite
Cite
Alex Kotak, Graham Merrick, Presentation of metastatic renal cell carcinoma as a lip lesion, Journal of Surgical Case Reports, Volume 2014, Issue 9, September 2014, rju083, https://doi.org/10.1093/jscr/rju083
Close - Share Icon Share
Abstract
We present a case of a 64-year-old gentleman who developed a renal cell carcinoma (RCC) metastasis to his lower lip following successful treatment of the primary tumour. RCC is a common kidney tumour but skin metastases are considered rare. The authors describe the findings of this case and discuss the presentation, investigations and management of RCC skin lesions.
INTRODUCTION
Renal cell carcinoma (RCC) also known as hypernephroma or adenocarcinoma of renal cells is the most common type of kidney tumour found in adults. It originates in the proximal convoluted tubules, typically affecting men with a peak incidence in 50–70 year olds [1]. The tumour is recognized to metastasize to common sites which include the lungs, liver, bone, adrenal glands and the brain. Cutaneous spread is considered a rare condition [2]. The authors present a case of a gentleman with RCC metastasis to the lower lip after a recent nephrectomy.
CASE REPORT
A 64-year-old male was referred by his general practitioner with concerns over an increasing swelling on his lower lip following unsuccessful control with antibiotics and antifungal treatment. At presentation he reported a 3-week history of an asymptomatic growth on his lower right lip, which he originally attributed to trauma whilst shaving. The lesion was ∼4 cm in diameter, soft, erythematous with overlying crusting (see Fig. 1).

At the time of presentation the patient was otherwise well. His regular medications included omeprazole and amlodipine. He had undergone a laparoscopic nephrectomy 6 months earlier as management of renal tumour. This had been shown histologically to be a Fuhrman grade IV clear cell RCC. He was an ex-smoker and alcohol intake was within safe limits.
The provisional diagnosis based on history and appearance was of a rapidly growing squamous cell carcinoma or keratoacanthoma.
An initial biopsy however showed features consistent with a metastatic adenocarcinoma consistent with the previously removed RCC (see Fig. 2).
Photomicrograph of a specimen from the lower lip demonstrating the presence of RCC cells.
Further staging with a computed tomography of the chest revealed a 15 mm pulmonary nodule in the right upper lobe anterior segment also consistent with metastatic disease. The patient was discussed at the head and neck multidisciplinary team meeting with consultation from his urology team. A decision was made to resect the rapidly growing lip metastases as part of local control of disease for functional and aesthetic reasons. The lip metastasis was excised using a wedge excision with 1 cm clearance margins (see Fig. 3). The lung nodules were later treated with chemotherapy and the patient is still under regular review.

Post-operative—following resection and repair of the lower lip.
DISCUSSION
RCC metastasis to the skin can present before diagnosis of the primary site but are typically found after the initial primary tumour identification [3, 4]. As in this case metastases can develop after initial nephrectomy. It is reported that 20–50% of patients having had a nephrectomy for RCC will develop distant metastases in the future [5]. This potential for distant metastases after primary treatment of RCC is one of the reasons for the poor prognosis in this type of tumour.
Skin presentations account for 1–3% of metastases. The scalp and face have been reported as the most common sites [6]. RCC metastases have been documented in the nasal cavity, lower lip, hard palate, tongue and maxillary sinus [7]. Presentation of skin lesions can be varied and lead to a wide variety of differentials. These could include pyogenic granuloma, haemangioma, melanoma, basal cell carcinoma and other vascular lesions. Biopsy is the gold standard for diagnosis and should be taken in all situations. Imaging is of little use for skin lesions but can help locate other sites of metastases. One review of cutaneous metastases in RCC showed 90% of patients had secondary tumours in non-cutaneous sites such as the lungs and bones [8]. Treatment of skin lesions can vary depending on the site; however, excision is recommended if the scalp or face is involved. Multi-disciplinary team discussion is critical in deciding the mode of treatment of other secondary sites of metastasis, e.g. lung and bone.
Skin metastases from RCC are rare but some cases have been documented. They can present before or after RCC diagnosis and despite removal of the primary tumour metastases can present many years later. The prognosis of patients with skin involvement is typically poor. A high index of clinical suspicion is needed and a thorough history and examination should be obtained. Patients with known RCC should be monitored due to the likely appearance of metastases at multiple secondary sites.
Conflict of interest statement
None declared.